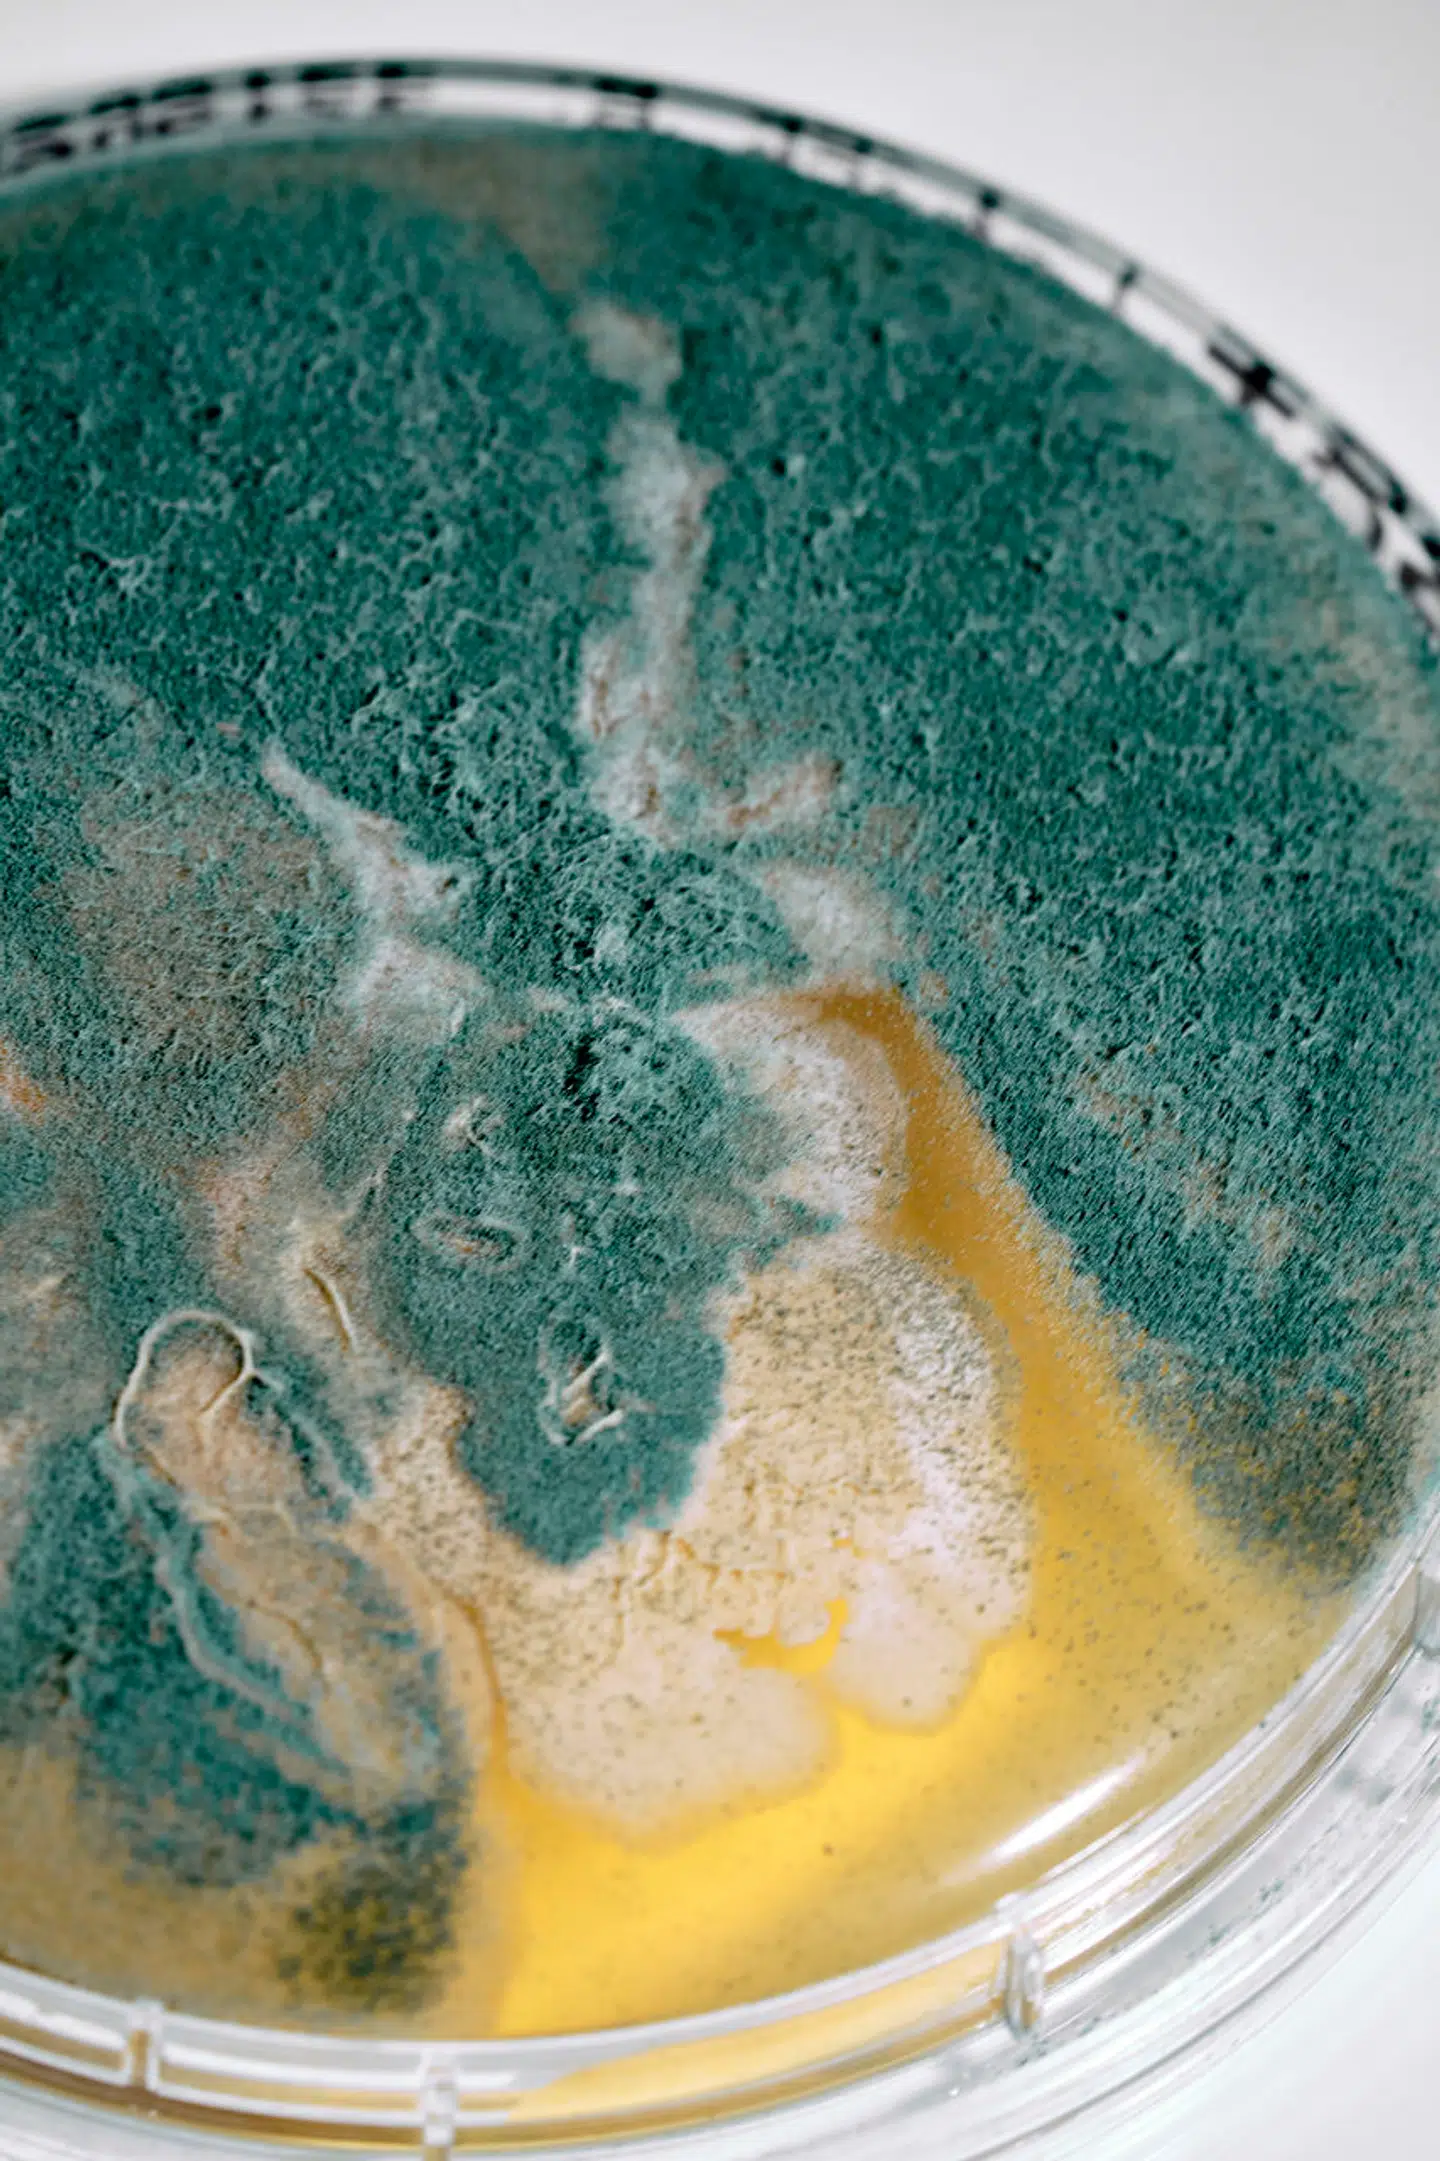
I 2023 fandt Rigshospitalet ud af, at skimmelsvampen Aspergillus fumigatus voksede på kræftafdelingen for børn. Forskere er særligt bekymret for netop den svamp, da den både kan vokse i mennesker og er begyndt at udvikle resistens, så patienter, der bliver syge af svampen, ikke kan behandles med den medicin, vi har til rådighed.
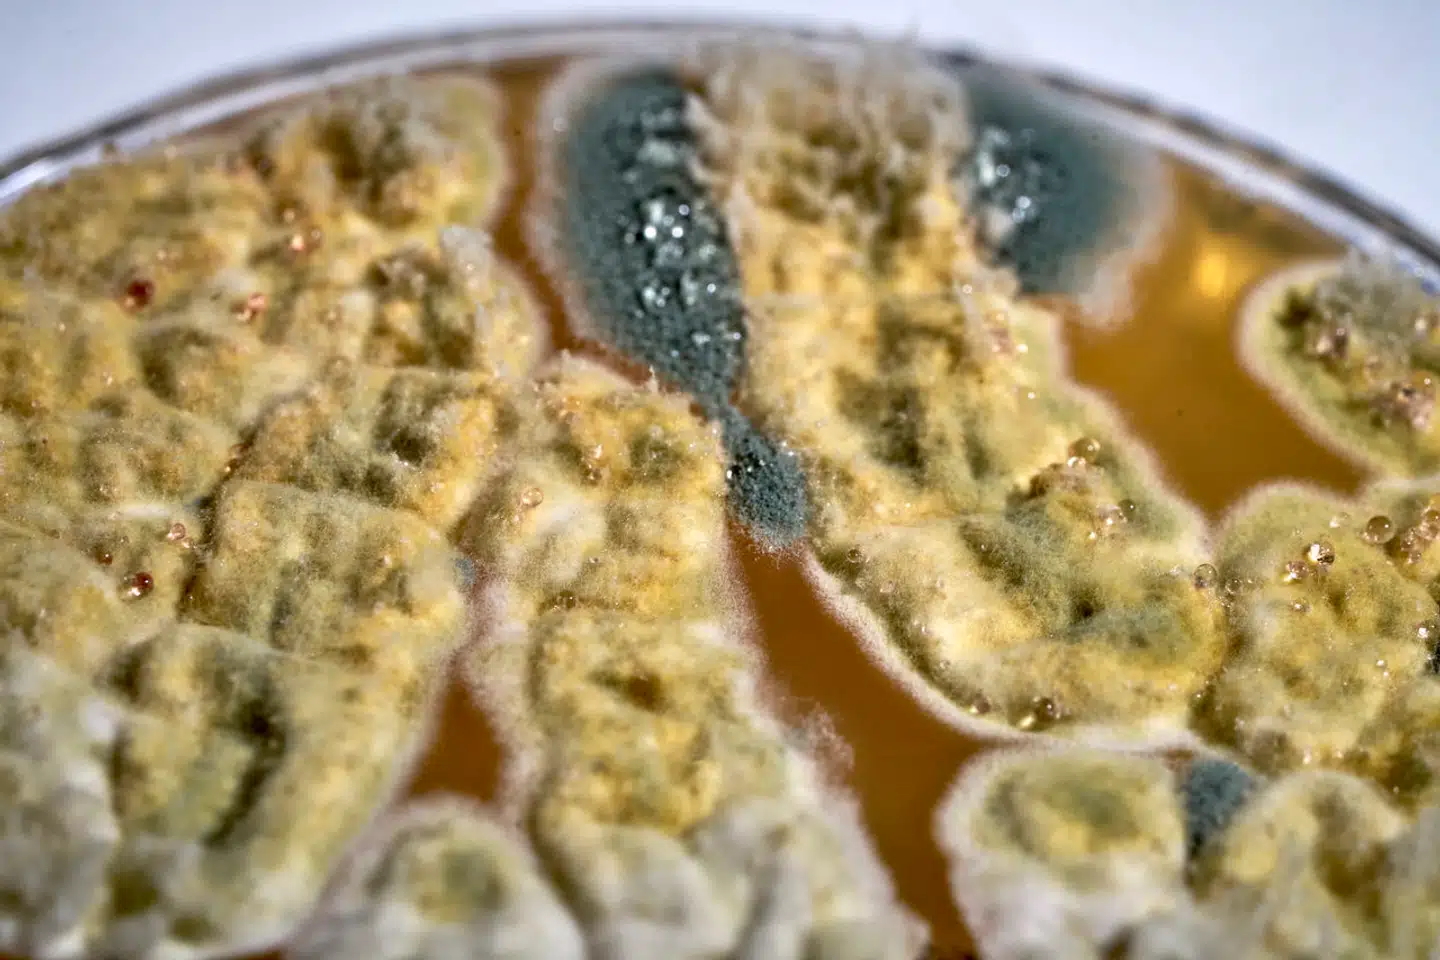

De seneste fem år er der fundet mindst 26 forskellige slags skimmelsvampe i væggene og gulvene på Rigshospitalet.
Nogle er ganske harmløse.
Men andre kan give fatale infektioner i lungerne og hjernen.
Nogle angreb af skimmelsvamp er så voldsomme, at Rigshospitalet har måttet fjerne vægge eller brække gulve op for at komme problemet til livs. Det er sket på både sengestuer, badeværelser, operationsstuer og i venteværelser.
Det viser blandt andet en aktindsigt i alle de fund af skimmelsvamp, Rigshospitalet har gjort de seneste fem år.
I 2020 tog det for eksempel måneder at sanere den skolestue, hvor kræftsyge børn får undervisning.
Men Region Hovedstaden har undladt at løse kilden til problemet, selvom problemet har været kendt i årevis
Det kan Berlingske afsløre efter at være dykket ned i renoveringsplaner fra de seneste år. Og det bekræftes af fagfolk som Niels Høiby, der er overlæge på Rigshospitalet og professor i klinisk mikrobiologi.
»Det er desværre ikke nyt, at der er fundet skimmelsvampe på hospitalet. Svampene opstår, når man har et ventilationssystem, som giver kondens. For når der er fugt, risikerer man jo at få skimmelsvamp,« siger lægen, som også har siddet i regionsrådet for Liberal Alliance fra 2013 til 2017.
Derfor er det også et problem, at Rigshospitalet ikke får fjernet kilden til skimmelsvampene, siger han.
For de skimmelsvampe, Rigshospitalets ansatte finder i hospitalets vægge, kan give særlig sårbare patienter fatale infektioner.
»Det er godt nok ærgerligt, at der er de her fund af skimmelsvamp. Vi har forsøgt at undgå, at det rammer særligt udsatte patienter, der har fået en organ- eller knoglemarvstransplantation, og patienter på en hæmatologisk afdeling, der skal have kemoterapi, og lignende særligt udsatte,« siger Niels Høiby.
Det er især i den bygning, der hedder Sydkomplekset, at der er problemer med skimmelsvamp, og i den bygning ligger de afdelinger, hvor netop de patientgrupper, Niels Høiby nævner, er indlagt.
Lørdag kunne Berlingske afsløre, at syv børn har fået en infektion med skimmelsvamp, som resultat af den behandling de fik på Rigshospitalet.
Søndag kunne Berlingske fortælle, at der er fundet mere skimmelsvamp på hospitalet, end de grænseværdier hospitalet selv arbejder med, 110 gange siden 2018.
Nu viser det sig, at problemerne har været kendt i en årrække.
De seneste syv år har flere rapporter, som regionen og Rigshospitalet selv har bestilt, slået fast, at bygningerne i København er i dårlig stand, og at der derfor er risiko for skimmelsvamp.
Men allerede længe inden da var de advaret om, at de havde problemer med skimmelsvamp.
Nogle gange tager det måneder, før hospitalet får bugt med de sorte svampe. Det bekræfter ansatte, som Berlingske har talt med.
»Man taler meget om skimmelproblemerne blandt personalet, men jeg har aldrig hørt ledelsen sige noget om det,« siger en sygeplejerske, som arbejder med fødselsområdet og har betinget sig anonymitet for at deltage i Berlingskes artikel.
Rigets tilstand
Kort fortalt er Rigshospitalets lidelseshistorie om skimmelsvamp et spørgsmål om fugt.
Der har de seneste år været vandskader fra ødelagte vandrør og fra vand, der er trængt ind fra ydermurene. Hospitalet har også haft problemer med gamle afløb og radiatorer, der lækker vand.
I 2018 afleverede den rådgivende ingeniørvirksomhed Rambøll en rapport til Region Hovedstaden, hvor de konstaterede, at Rigshospitalet ganske enkelt forfalder, mens patienterne stadig er der.
Kort sagt er sygehuset det hospital i regionen, der er i dårligst stand.
Derfor har man blandt andet spændt et net ud over facaden på hospitalets højeste bygning, fordi man er bekymret for, at sten fra ydermurene falder ned i hovedet på forbipasserende.
Og klimaskærmen – alle de dele af en bygning, der holder vejr og vind ude – bliver ganske enkelt betegnet som »nedbrudt« med »utætte tage og facadeelementer« og netop »problemer med skimmelsvamp« til følge.
For at komme problemerne på Rigshospitalet til livs bad Region Hovedstaden i 2019 rådgivende ingeniører hos virksomheden ISC om at udarbejde en plan for, hvordan hospitalet kunne renoveres, mens patienterne fortsat fik den behandling, de havde krav på.
Her kan man læse fire problemer, der kan give skimmelsvamp i den bygning, der hedder Sydkomplekset.
Det er også her, Rigshospitalet flest gange har fundet skimmelsvampe på afdelingerne.
For det første er installationer som vandrør, ventilationsskakter og sågar elinstallationer så udtjente, at de skal udskiftes.
For det andet kan en kuldebro fra uopvarmede betondæk give skimmelsvamp.
For det tredje lever de eksisterende ventilationssystemer i Rigshospitalets Sydkompleks, det, ISC-rapporten kalder Sydfløjen, ikke op til hverken hygiejnekrav eller nutidens krav om luftskifte.
Og sidst, men ikke mindst, er vandrørene ødelagte og skal skiftes. Blandt andet fordi de består af to materialer, der tærer på hinanden.
I en bygningsanalyse, som regionen selv udarbejdede i 2021 for at give et »øjebliksbillede af tilstand, kvalitet og funktionalitet« for Rigshospitalet, kan man læse, at der har været mange tilfælde af vand- og skimmelskader de seneste år.
Tre vandskader og inflation
Netop på grund af den ødelagte klimaskærm og de tærede vandrør har der været mange vandskader på Rigshospitalet:
I 2021 drev vandet fra neonatalafdelingen på anden sal i Sydkomplekset og ned på kræftafdelingen på første sal.
I 2022 begyndte ansatte på hospitalet at kalde en afdeling for akvariet, fordi der flød vand ud på gulvene efter et sprængt vandrør.
I 2023 har der været lukket af på flere stuer på kræftafdelingen for børn, fordi en omfattende vandskade betød, at der igen kom skimmelsvampe på afdelingen.
»I sidste ende handler Rigshospitalets problemer med skimmelsvampe om, at de har et problem med fugt,« siger Suzanne Gravesen, tidligere seniorforsker på Statens Byggeforskningsinstitut, som har viet sit arbejdsliv til at undersøge skimmelsvampe.
Allerede i 1990erne undersøgte hun en afdeling på hospitalet for skimmelsvamp.
»Dengang fandt jeg en del skimmel i fugerne på badeværelserne. Så man må sige, at de selv har været opmærksomme på det allerede da.«

Men kilder i regionen oplyser, at regionen på grund af sparehensyn kun tester for skimmelsvamp, hvis de bliver bedt om det af ansatte på hospitalet. Og der er heller ikke råd til at skifte vandrørene, selvom man faktisk satte penge af til det i 2018.
De seneste år har regionen måttet konstatere, at de syv milliarder kroner, politikerne i 2018 satte af til at reparere regionens hospitaler over en tiårig periode, ikke længere slår til.
Egentlig viser planen for renovering af hospitalerne, at der i 2024 skulle afsættes 588 millioner kroner til at fikse regionens hospitaler.
Men i det budget for 2024, som regionens politikere vedtog i september, blev der kun afsat omkring 97 millioner kroner.
Regionens ansvar
Regionen har ifølge ekspert i sundhedsret Kent Kristensen slet ikke reageret hurtigt eller godt nok.
»Man skal hverken bruge fem eller ti år på reparere kilden til skimmeludbruddene, hvis man ved, hvad den er. For den tid, der går, er jo den tid, hvor man udsætter patienterne for en risiko, som man har pligt til at undgå,« siger han.
Det er ifølge Ken Kristensen regionens ansvar, hvad enten de har råd eller ej.
»De har et ansvar for at sikre, at behandlingen er sundhedsfaglig forsvarlig. Og det har de, uanset hvilken økonomi de har.«
I Region Hovedstaden erkender formand for sundhedsudvalget Christoffer Buster Reinhardt (K), at det er regionen, der har fejlet, når Rigshospitalet igen og igen finder skimmelsvamp på de afdelinger, hvor hospitalets svageste børn ligger.
»Men det her handler jo også om, at vi har en række gamle hospitaler, som vi ikke har råd til at renovere, fordi pengene bliver nødt til at blive brugt på nybyggeri, så vi har måttet stoppe hele vores renoveringsplan,« siger han.
Det skyldes, siger han, at regeringen ikke har villet hæve det beløb, regionen må bruge på anlægsudgifter.
Sundhedsminister Sophie Løhde (V) er enig i, at det er regionens og hospitalets ansvar at sørge for, at der ikke opstår skimmelsvamp på sygehusene.
Hun ønsker ikke at stille op til et interview, men sender i stedet en skriftlig kommentar i en e-mail:
»Regionerne er ansvarlige for at vedligeholde sygehuse og andre regionale bygninger inden for de anlægsrammer, der er aftalt i de årlige økonomiaftaler. Fra regeringens side har vi foreslået, at der etableres en sundhedsfond, hvor pengene blandt andet kan gå til at vedligeholde og modernisere sygehuse.«
Men den besked falder ikke i god jord i regionen.
»Vi har simpelthen ikke nok penge på anlægsrammen, og regeringen har ikke været villig til at øge det beløb, vi kan bruge. Når vi ikke har penge til at renovere de gamle hospitaler nu, bliver det dyrere at renovere dem på sigt,« siger Christoffer Buster Reinhardt og tilføjer:
»Så ministeren kan godt sige, at det er vores ansvar, men vi har jo kun de penge, vi får tildelt af staten.«
I Region Hovedstaden oplyser presseenheden, at de er enige i Christoffer Buster Reinhardts udlægning.
Regionen forventer at kunne lægge en ny plan for at renovere sine hospitaler i 2025.
Rigshospitalet oplyser, at det ikke er muligt at flytte patienter fra afdelinger, hvor der findes skimmelsvamp:
»Flytning af patienter til et andet sted, eliminerer ikke risikoen og vil desuden fjerne patienterne fra den ekspertise, der er nødvendig for at varetage de meget komplicerede behandlingsforløb, hvor risikoen for svamp kun er et risikoelement. Den aktuelle ikke-øgede forekomst af svampeinfektioner, og ikke mindst den meget høje overlevelse for denne intensivt behandlede patientgruppe, dokumenter effekten og forsvarligheden i Rigshospitalets aktuelle strategi.«


